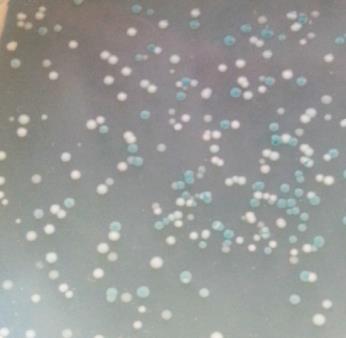
产品细节图片2

相关产品推荐更多 >
万千商家帮你免费找货
0 人在求购买到急需产品
- 详细信息
- 文献和实验
- 技术资料
- 库存:
50
- 英文名:
pUCm-T载体
- 保质期:
一年
- 供应商:
上海信裕生物科技有限公司
- 保存条件:
-20℃保存。
- 规格:
20次
pUCm-T载体(pUCm-T Vector)是用于克隆含有A末端PCR产物的理想载体。可以通过蓝白斑筛选有插入片段的重组克隆。
很多DNA聚合酶在进行PCR扩增时会在PCR产物双链DNA每条链的3'端加上一个突出的碱基A。pUCm-T载体是一种已经线性化的载体,载体每条链的3'端带有一个突出的T。这样,pUCm-T载体的两端就可以和PCR产物的两端进行正确的AT配对,在连接酶的催化下,就可以把PCR产物连接到pUCm-T载体中,形成含有目的片段的重组载体。
| pUCm-T载体的主要信息如下: | |
| Base pairs | 2773 |
| Lac Z promoter | 142-171 |
| M13/pUC Reverse Primer | 204-221 |
| Lac Z | 222-534 |
| Multiple cloning region | 233-376 |
| M13/pUC Sequencing Primer | 378-395 |
| Synthetic Beta-lactamase (Ampr) coding region | 972-1832 |
| ColE1 origin of replication(rep) | 1987-2606 |
pUCm-T载体的图谱如图1:

图1. pUCm-T载体图谱示意图
pUCm-T载体的多克隆位点的详细序列如下(请特别注意其中的Pst I不是单酶切位点):
| Lac Z | |||||||||||
| 201 | ACACAGGAAA | CAGCTATGAC | CATGATTACG | CCAAGCTTGC | ATGCCTGCAG | ||||||
| TGTGTCCTTT | GTCGATACTG | GTACTAATGC | GGTTCGAACG | TACGGACGTC | |||||||
|
|||||||||||
| 251 | GTCGACTCTA | GACTCGAGGG | ATCCAGATCT | CCAGTCTT GA | CCTGGTCTGC | ||||||
| CAGCTGAGAT | CTGAGCTCCC | TAGGTCTAGA | GGTCAGA TCT | GGACCAGACG | |||||||
|
|||||||||||
| 301 | AGGCGGCCGC | CCATGGGATA | TCATCGATCA |
|
|||||||
| TCCGCCGGCG | GGTACCCTAT | AGTAGCTAGT |
|
||||||||
| Kpn I Sac I EcoR I | |||||||||||
| 351 | CGTATTACGG | TACCGAGCTC | GAATTCACTG | GCCGTCGTTT | TACAACGTCG | ||||||
| GCATAATGCC | ATGGCTCGAG | CTTAAGTGAC | CGGCAGCAAA | ATGTTGCAGC | |||||||
pUCm-T载体中没有的酶切位点(Restriction enzymes that do not cut pUCm-T)包括:
| Afl II | Age I | Apa I | Asc I | Avr II | Bbs I | Bbv II | Bcl I |
| Blp I | BsaA I | BseR I | Bsg I | BsiC I | BsiW I | Bsm I | BsmF I |
| Bsp120 I | BspM II | BsrG I | BssH II | Bst1107 I | BstB I | BstE II | BstX I |
| Bsu36 I | Dra III | Eco47 III | Eco72 I | Esp I | Fse I | Hpa I | Mlu I |
| Msc I | Mun I | Nae I | NgoM I | Nhe I | Nru I | Nsi I | PflM I |
| Pme I | Pml I | PpuM I | PspA I | Rsr II | Sac II | Sfi I | Sma I |
| SnaB I | Spe I | Spl I | Srf I | Stu I | Xca I | Xma I |
pUCm-T载体中的单酶切位点(Restriction enzymes that cut pUCm-T once)包括:
HinD IIIA`AGCT,T234Acc65 IG`GTAC,C360BspM IACCTGC 10/14239Asp718G`GTAC,C360Sph IG,CATG`C244Kpn IG,GTAC`C364Sal IG`TCGA,C252Ban IIG,RGCY`C370Acc IGT`MK,AC253Sac IG,AGCT`C370HinC IIGTY|RAC254Apo IR`AATT,Y372Hind IIGTY|RAC254EcoR IG`AATT,C372Xba IT`CTAG,A258Kas IG`GCGC,C533Ava IC`YCGR,G264Nar IGG`CG,CC534PaeR7 IC`TCGA,G264Ehe IGGC|GCC535Xho IC`TCGA,G264Bbe IG,GCGC`C537BamH IG`GATC,C270EcoO109 IRG`GNC,CY780BsaB IGATNN|NNATC275Aat IIG,ACGT`C841Bgl IIA`GATC,T276Ssp IAAT|ATT955Xcm ICCANNNN,N`NNNNTGG289Xmn IGAANN|NNTTC1160Tth111 IGACN`N,NGTC293Bsp1286 IG,DGCH`C1177Not IGC`GGCC,GC305Sca IAGT|ACT1279Eag IC`GGCC,G305EcoN ICCTNN`N,NNAGG1399Xma IIIC`GGCC,G305Cfr10 IR`CCGG,Y1675Dsa IC`CRYG,G312Bsa IGGTCTC 7/111694Nco IC`CATG,G312Ahd IGACNN,N`NNGTC1760Sty IC`CWWG,G312AlwN ICAG,NNN`CTG2239EcoR VGAT|ATC320Afl IIIA`CRYG,T2648Cla IAT`CG,AT325Sap IGCTCTTC 8/112765pUCm-T载体的全序列信息: D2006 pUCm-T vector-seq.txt
pUCm-T载体是在pUC19载体的基础上改造而成,除多克隆位点外,其余序列同pUC19(GenBank Accession Number
M77789)。
少量自连的载体转化得到的克隆由于编码了LacZ基因,而在IPTG/X-Gal平板上呈现蓝色。大部分重组的载体,由于插入片段破坏了LacZ基因,因而在IPTG/X-Gal平板上转化得到白色克隆。这样就可以通过蓝白斑非常容易地筛选出重组克隆,蓝白斑筛选结果示意图如图2。
图2. pUCm-T载体的蓝白斑筛选结果示意图。pUCm-T载体和PCR产物片段进行连接,转化后在IPTG/X-Gal平板的上长出的克隆,其中白色克隆代表PCR产物片段可能插入到pUCm-T载体中,但后续还需要酶切、PCR或者测序确认。
图2. pUCm-T载体的蓝白斑筛选结果示意图。pUCm-T载体和PCR产物片段进行连接,转化后在IPTG/X-Gal平板的上长出的克隆,其中白色克隆代表PCR产物片段可能插入到pUCm-T载体中,但后续还需要酶切、PCR或者测序确认。
对于重组的质粒可以使用载体多克隆位点上的两个PstI酶切位点进行PstI单酶切鉴定,也可以使用廉价且高效的EcoRI、
BamHI、XbaI、HindIII等内切酶进行双酶切鉴定。
构建完成的质粒可以通过质粒上的正反两个M13引物位点进行测序或通过T7 promoter上的T7引物位点进行测序。
构建完成的质粒可以利用T7 RNA polymerase promoter进行体外转录,用于探针标记等。
一个包装的本载体共可以进行20次连接反应。
包装清单:
| 产品编号 | 产品名称 | 包装 |
| XY-2006 | pUCm-T载体 | 20μl |
| — | 说明书 | 1份 |
保存条件:
-20℃保存。
注意事项:
本质粒未经信裕生物书面许可不得用于任何商业用途,也不得移交给订货人所在实验室外的任何个人或单位。
DNA聚合酶是否可以在PCR产物3'端加A需参考该DNA聚合酶的说明。对于PCR产物为平端的情况,不适合用于T载体的连接反应。对于平端的PCR产物可以先进行在3'端加A的反应,再用T载体进行克隆。
进行PCR产物克隆时需自备连接、转化等相关试剂、试剂盒。
本产品仅限于专业人员的科学研究用,不得用于临床诊断或治疗,不得用于食品或药品,不得存放于普通住宅内。
为了您的安全和健康,请穿实验服并戴一次性手套操作。
风险提示:丁香通仅作为第三方平台,为商家信息发布提供平台空间。用户咨询产品时请注意保护个人信息及财产安全,合理判断,谨慎选购商品,商家和用户对交易行为负责。对于医疗器械类产品,请先查证核实企业经营资质和医疗器械产品注册证情况。
 文献和实验
文献和实验相关专题 那些实验室常用的克隆载体 pUC质粒载体是重要的大肠杆菌质粒载体之一,一起看下pUCm-T质粒图谱 和序列吧。 pUCm-T质粒图谱 pUCm-T载体 序列
在丁香园见过很多大佬分享载体构建经验,所以我这里写的T载体构建只能算是入门级,给新手提供一点思路,有什么不足之处还希望大家多多指正。 我克隆的这个片段大小是1.8kb,用的是TaKaRa的LA-Taq酶做的PCR。 反应体系:5*buffer 5 ul MgCl2 5 ul dNTPs 8 ul Primer 1 1 ul Primer 2 1 ul LA-Taq 0.5 ul cDNA 1 ul (1ug左右基因组DNA) ddH2O up to 50 ul
Making the T-vector: 1.Digest 5 ug of vector DNA ( pBluescript & pUC18) with a restriction enzyme that generates a unique blunt end site, for example EcoRV or Sma I ( we prefere EcorV for it's stable activity at 37 C) for 2 hours at 37 C. 2.Run
 技术资料
技术资料暂无技术资料 索取技术资料










